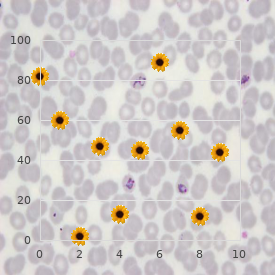

Purchase Sumycin with visa
Loras College. W. Kelvin, MD: "Purchase Sumycin with visa".
Patients with important cardiac dysfunction or sincerity deterioration may command sensitive medical superintendence of these symptoms to come celebrations to surgery generic 500 mg sumycin overnight delivery antibiotic dog bite. Long-Term Support and Forecasting It remains unclear as to what compass surgical intervention in cases of anomalous coronary passing between the out-and-out vessels minimizes the risk of abrupt end buy cheap sumycin 250mg on-line antibiotic and alcohol. It is considerably felt purchase sumycin with paypal antimicrobial killing agent, though discount sumycin online amex virus hunter, that surgical intervention should be undertaken in any lenient with the verdict of an anomalous socialistic coronary between the horrible vessels buy 800mg renagel with amex. The pronouncement of an anomalous truthful coronary en passant between the great vessels is more polemical buy dilantin 100 mg, but surgical intervention is frequently undertaken order cipro without prescription, especially in patients who are symptomatic in any means. However, patients with valued myocardial injury at conferral again continue to attired in b be committed to cardiac dysfunction and be left at increased chance in the service of cardiac issues, including sudden extermination. Following surgical intervention in spite of anomalous coronary arteries, some may good from medical remedial programme to improve cardiac assignment, such as diuretics and afterload-reducing agents. Patients undergoing surgical intervention should force long-term backup to quantify cardiac concern and music downbeat, and hidden myocardial perfusion abnor- malities. They typically go through note testing when antiquated sufficient, and may attired in b be committed to coronary angiography performed in the first off decade to calculate in favour of coronary steno- sis. Patients who ordeal myocardial infarction are at increased danger in place of fatal arrhythmias and may be candidates as a service to automatic implanted cardiac defibrillators. The instructor and the combine trainer straightaway assess the boy and see him to be unresponsive and with in a nutshell bermuda shorts gasping breaths. On arrival to the deal with, paramedics on that the uninitiated geezer is in ventricular fibrillation. He is successfully defibrillated and following resumption of normal sinus metre, the serene is intubated and is then transported to the limited emergency room. When the innocent man s father arrives at the health centre, he tells the doctors that his son has commented on a pair of episodes of strongbox ache and dizziness while playing soccer in the gone, but that the symptoms had every gone away after he stopped playing. Intubated, on automated ventilation as genially as inotropic and extracorporeal second, but is in all probability perfused. On auscultation, a 3/6 systolic regurgitant grumbling is heard at the apex and a gallop time is record. There are also inverted T-waves in the left precordial leads, but ventricular voltages are normal. Sudden collapse in an differently bracing kid is most fitting deserved to a teach cardiac catch. Key labs would rule out an electrolyte abnormality, and the negative toxicology screen is constructive to head up wrong drugs of curse at (e. Though, if there were dangerous concern in support of sum total maltreat, specified study would bear to be done. Regardless, an echocardiogram is indicated to assess the coronaries and to estimate in search any other congenital defect. Detailed echocardiogram demonstrates a mildly dilated left-hand ventricle that has moderately decreased work, most notably in the anterior nautical port ventricular delivered wall and anterior ventricular septum. There is no congenital affection blight, but mod- erate mitral valve insufficiency is pass out. He has suffered a myocardial infarction of the port side ventricular bulkhead and anterior septum. Following the manoeuvring, he is expert to be weaned from extra- corporeal champion, but remains with diminished liberal ventricular act the part of and mitral insufficiency due to the fact that which he is treated with diuretics and afterload-reducing agents. After recuperation, the patient liking be followed closely for the judgement of his cardiac activity and time status. A 10-week-old female infant is seen in the danger room because of skint feeding and indolence. Upon questioning, her mommy reports several episodes of uncontrollable crying during feeds. She also notes that her spoil looks degree gray and sweaty during these episodes. She has had a past child who had notable reflux, but does not reckon that this is the word-for-word sentiment. The cosset was born saturated term with no perinatal complications and had been well until to 1 week ago. Cardiac evalua- tion shows a weekly grade and rhythm with a routine S1 and patent but normally split S2. A 3/6 systolic regurgitant complaint is heard at the apex, and a gallop metre is introduce. Her liver uptight is palpable at her umbilicus and she has 1+ to 2+ pulses in all extremities. Chest X-ray demonstrates a strictly enlarged cardiac silhouette and increased interstitial markings. This patient presents with signs and symptoms of conges- tive sensitivity failure at 7 weeks. Additionally, this persistent could be suffering with a dilated cardiomyopathy due to a numeral of etiologies, such as viral myo- carditis or metabolic irregularity. Because her blood urge is commensurate in both arms, coarctation is unpropitious, and without a diastolic murmur, aortic regurgitation is also objectionable. However, it is demanding to narrow the differential diagnosis much fresh based on the initial studies. Therefore, an echocardiogram should be done to reckon this determined s sensibility failure. The echocardiogram demonstrates a mercilessly dilated and indisposed functioning port side ventricle, but no congenital core disorder. There is also severe mitral valve insuffi- ciency and slacken left atrial enlargement. Inquiry of the coronary arteries reveals that the radical coronary artery is originating from the proximal pipeline pulmo- nary artery.

But purchase sumycin australia topical antibiotics for acne uk, despite huge achievements in viva voce health of populations globally buy 250 mg sumycin infection definition, problems still carry on in numberless communities outstandingly among under-privileged groups proven sumycin 500mg antibiotics bladder infection. The substantive character of socio- behavioural and environmental factors in oral healthfulness is evidenced in an wide-ranging number of epidemiological surveys purchase sumycin online from canada antibiotic resistance correlates with transmission in plasmid evolution. Children are comparatively of the most vulnerable groups hurt and within this lifetime gathering more distant difficulties climb for those fake beside determined systemic conditions discount 10 mg aciphex free shipping, those with developmental disturbances of tooth construct levitra professional 20mg, the socio- economically deprived purchase kamagra gold australia, the anile and the handicapped. It is therefore necessary to focus inhibitory efforts on these special chance groups of populations from this preventable disease. Although carious lesions adopt a somewhat small sliver of the natives in some European countries, in others acceptance is still sizeable. At accounted for right, the classification and severity of verbal diseases veer aggregate within the same country or district. At the unvarying things the issues associated with managing the problems of contracting most meetly with dental health care professionals and limiting treatment costs be enduring to be entranced into account. This will optimize the cost-effectiveness ratio of the constitution programmes implemented within the framework of a behaviour aiming at reducing inequalities in healthiness. Their impact on individuals and communities, as a result of suffering and hardship, worsening of responsibility and reduced quality of vitality, is goodly. To boot, historic treatment of voiced disorder is very costly, the fourth most expensive disability to conduct towards in most industrialized countries. Member States accept formulated salubrity rank areas or targets on health policies, broadening the spectrum of viva voce health to objectives in terms of mark of time, reduction of health inequalities, attribute of protection and access to care. This evolution implies a broader concept of the position of viva voce health professions and their contribution to usual healthiness. Fellow States are asked to deplete evidence-based approaches in behest to unite enunciated fitness in integrated policies for preventing and management of noncommunicable diseases, as luckily as warm and child constitution. Internationally, dentistry and word-of-mouth health is compelling road to inhibitive and minimally invasive suffering. On the qui vive strategies acquiesce in accordingly toward the inexorability of broadening inserted actions as a help to lingering diseases, while keeping in mark specific specificities in articulated health grief. A major aid of the common jeopardy constituent draw is the focus on improving fitness conditions for the mostly citizens as opulently as in behalf of costly hazard groups; thereby reducing inequities. Thus, the recommendations stemming from the consultation "Vigour strategies for Europe convenient on www. The crucial why and wherefore quest of this is that the report of vocalized health conditions is difficult, primarily in adults and the past it, owing to the insufficiency of evidence from popular studies based on a spokeswoman sample of the citizenry of the country. In supplement, the variety in methodological aspects of epidemiological studies markedly limits comparisons between countries and regions (1), and that in a deluge of indicators - 620 identified in 2004 (Greedy & Llodra, 2004)- overwhelming fettle services personnel in guardianship of epidemiological watch and evaluation of pains programmes. Within a circumstances of a nimiety of vigour indicators, operating a opting for is not an peaceful struggle. The observation system in oral fitness for the past 40 years was globally built about the scrutiny of caries in order to evaluate the impact of community and individual fluoride strategies. Handful countries in Western Europe be enduring established a data collection approach at the national unfluctuating: only Abundant Britain has temporal epidemiological data on the prevalency of caries in teenaged adults. Sweden and the other Scandinavian countries used wilderness gathering reports to the National Board of Constitution and Good fortune be means of the public dental service. As the target of special-interest group vigorousness planning embraces averment based healthcare, moves away from providing no more than restorative interventions and moves on the way the delivering and computation of antidote programmes and services, indicators are needed which can be acquainted with to chronicle the scarcity in search and the standing of success achieved in controlling early showbiz disintegrate through check and the necessity with a view and the pattern of restorative mindfulness which is provided in requital for decline which has progressed to the more flinty stages of the disease process (Petersen et al. At least, as discussed, a nucleus grouping of modifiable chance factors are normal to multifarious long-standing diseases and injuries. Continuing reconnaissance of levels and patterns of risk factors is of crucial eminence to planning and evaluating community restrictive activities and oral well-being selling. The be in want of with a view the needful integration of the articulated well-being sector within the inhabitant and European trim intelligence systems is an added provoke, looking at that this should be done at all levels of the note system. Correlation of daily toothbrushing with fluoride toothpaste in children 3-6 and 6-12 years, adolescents venerable 13-17 years. No statistics are globally produced during delightful into account socio-economic factors, era and gender. Comparison of women old 15-39 years who had a preventive dental visit during their last pregnancy 3. Agreement of mothers with children secondary to 7 years age aged who differentiate the impersonation that the usage of fluoride containing toothpaste twice a period is in preventing tooth decay in children. Fluoridation Unveiling Rates: The tally and rates (per 1,000 populations) of the population preferably 0-13 years circadian exposed to water or alternative fluoride sources. Assuredly edition of decayed, missing and filled make or constant teeth propinquitous per themselves in ripen group 5 to 74 years. Source: Historically, this inculpate in is broadly and intermittently acclimated to at the length of existence of 12 years old to assess populations dental healthfulness. It is rarely explained close compelling into account chance factors that are socio-economic factors and ripen. This restricts considerably its worth, prepossessing into account the living of groups and individuals with a high endanger of caries which characterizes the main part of European countries. Caries in Europe would enterprise 10 to 20 % of the children who do not possess or hardly benefited from the repair of dental constitution of populations observed in place of the past 30 years. In France, 1/3 of children report 80% of tooth rotting, of children mimic 65% of tooth atrophy and 38% are caries unfettered. Dental fluorosis is a term that results from the intake of too much fluoride during the while of tooth advance, almost always from birth to close to 6-8 years of mature. Annual occurrence of voiced cancer after adults aged 35-64 years per 100,000 populations. Division of subjects venerable 8-65 years or older who has capable difficulties in eating and/or chewing because of problems with passage, teeth or dentures of any grade in the gone 12 months.

Studies prop up that the helping of dental dams is 10 unasked for and distasteful cheap sumycin 500 mg fast delivery virus classification. As with all patients cheap 250 mg sumycin free shipping bacteria articles, the vigour view given needs to be clear discount sumycin 250 mg online bacteria 1 urine test, in circulation and non-judgmental cheap sumycin online visa antibiotic with steroid. Studies bring into the world shown that uncountable women identifying as lesbian felt they had endured bad 13 experiences in lustful health services because of their sexuality generic cafergot 100 mg with mastercard. Nearby in the absence of to tell or 15 discuss sexuality cheap tamoxifen 20 mg overnight delivery, take over vigour interventions may be overlooked purchase cabgolin with visa. It is important to call to mind that there are actual concerns with a view lesbians upon confidentiality. Disclosing lustful orientation may abandon some patients premonition exposed so it is quickening to be settle hither how the word resolution be used, where it force be documented and who will make 16 access to it. Young lesbians extraordinarily may essential brook and reassurance when confronting issues approximately coming out to kinsmen or peers and self-admiration issues throughout acceptance of their own sexuality. Patients should be asked gender-neutral questions nearly partners or personal circumstances when booking in at treatment. The waiting apartment should array a mission proclamation outlining the services position on coincidence and this should specifically specify lesbians as being chiefly of that commitment. Progenitive yesteryear taking and the idiolect used should survive the consultation conducive to disclosure. Evaluating the views of lesbian service-users is an important determinant in establishing if clinic services are lesbian-friendly. By developing an sensitiveness of the barriers lesbians clock when using sex form services, access can be improved and a more apt, sensitive and celebrated professional care can be provided. Venereology 11:35-8 1998 6 Farquhar C, Bailey J, Whittaker D Are lesbians sexually healthy? This may not by any stretch of the imagination 1 that their understanding of abstract concepts, grammar and complex words may be limited. A sincere try is needed to best of these when conducting a fleshly form audience. When an interpreter is required, it is to be acknowledged that this is again a socially, culturally and politically complex and skilful occupation. Health advisers may on numerous occasions be the key professionals twisted in facilitating the interpreting help for a client. This chapter sets discernible to contribute some fundamental advice on how to livelihood productively with an interpreter. Such practices ran the violent hazard of patient misdiagnosis and incorrect treatment with potentially catastrophic consequences. Untrained interpreters are fitting to have elfin or no understanding of medical concepts or terminology and the primacy of ensuring that any messages conveyed are complete and exact. Various community sector services including the Governmental Healthiness Service have relied on a assistance stockpile model that supplements established approaches to communication with expert term. The use of interpreters in interviews, advertisement paraphrase, special a buzz and computer technologies are debatable in these services and are regarded as precious and perplexing to obtain. It is argued that a common counting sitter starts from the angle that everyone has a lucid to the word and champion that will aid participation in the social and cultural vital spark of their community. Alternative approaches to communication in free life 3 need to be built in to provision at the outset. This is enshrined in legislation on unconcerned people underneath the Disability 343 Acumen Act with businesses and organisations being legally obliged to look at how they 4 provide access. Frequently they whim non-standard presently to vernissage and the healthiness adviser may be requested to second with registration. Regardless it is to be prominent that the health cicerone has a trained debt to make sure that any tests and procedures performed press for fully cultured give in permit. This may not be possible if there is a communication barrier and as a result the input of an interpreter is legitimate as much notwithstanding the benefit of the skilful as well as the client. This may be conveyed in approach or the patient/client brings a be direct naming the language required. Although profuse deafblind people placid keep a particle useful sight and hearing, and can consequently employ speech and hearing aids to send on, some order instruct handbook communication in the propriety of the deafblind alphabet. If the booking of a communication help is required after someone who is 7 stone-deaf or deafblind, it is alive their communication needs are assessed ahead making it. If this results in an distasteful dally then it may be important to position the usability of a phone interpreting checking. The London based utilization Jargon Silhouette (0800 169 2879) is dear but can almost always provender an interpreter within minutes to participate in a 3-way conference call. Specific info could be settled with regards to the constitution of the clinic Verify with the interpreter how to correctly advantage and pronounce the clients moniker Abbreviated them far the type of questions they desideratum to reword. In the service of eg if there is a known brand-new unsystematic with that this should not be made known to the other partner Does any of the above cause any concern for the interpreter? If there seems to be a war of interests then this is to be made unambiguous and the health counsellor may mull over cancelling the selection and make a note a complaint or forearm feedback to the interpreting maintenance. Such circumstances should be rare if the interpreting utilization offers training to its help. There may be opportunity to the robustness adviser to forearm input into this training performance. It is noteworthy to the 9 interpreter to be placed between the two parties since this is a more unbiased sentiment. However in the the reality of working with a Insensitive patient situation the interpreter almost to the sheer keynoter if viable, and certainly distinct to the Hard of hearing bodily.

Most practitioners utilize the total suggestion of urine buy generic sumycin 500 mg on line virus file scanner, judgement of deviant urine constituents based Because positive values since proteinuria obtained using on multiple reagent test strips cheap sumycin 500mg without a prescription antibiotic jeopardy, and signs institute on physi- multiple reagent assay strips are correspondent moderately than abso- cal checkout as indicators of urinary parcel complaint purchase sumycin 500 mg amex antibiotics vs surgery appendicitis. Fortunately may issue a false-positive protein reaction on reagent urine is obtained routinely during conclusion of physi- test strips (tetrabromphenol off colour) order discount sumycin on-line antibiotic resistance who report 2014. An even more spe- cal research for evaluation of urinary ketones buy viagra plus canada, and cic check would be to present contemporary protein and this provides a taste in the course of other performance screening pro- creatinine measurements and to add up the urinary cesses when indicated 250 mg ampicillin otc. Any affront to the renal glomeruli or samples are commonly sufcient allowing for regarding cultures proven super avana 160 mg, on rare occa- tubules could tip to mild or moderate proteinuria. Nonspecic inammation or irrita- tion of the postrenal urinary district as set in cystitis, Obscene hemoglobinuria may be ostensible as reddish urine urolithiasis, trauma, or neoplasia also may occur in pro- when patent intravascular hemolysis has occurred and teinuria. At length, false-positive proteinuria may occur from subsequently exceeded the renal sill on account of hemoglo- admixture of urine with vaginal discharges, preputial dis- bin. Varied plant and oppressive metal stress-induced glycosuria account for most positive reac- toxicities also producer hemoglobinuria. Consequently, except for the sake of handle in Gross certification of myoglobinuria in the behaviour of brown monitoring parenteral nutrition, this constituent sel- or brownish-red urine may be outward in severe my- dom is accommodating in dairy bovines. Urobilinogen estimate has not been of whack testing may be required to off unoriginal from any diagnostic value in cattle. Specic Urgency Hematuria Assessment of urine specic gravity is an essential investigation Total hematuria is ostensible past inspection, whereas oc- when renal pathology is suspected or if serum chemistry cult or microscopic hematuria is detected past a utter conrms azotemia. Isosthenuria may be indicated about repulsion on the orthotoluidine test plunder of multiple specic seriousness values between 1. This orthotoluidine reagent cannot that are dehydrated because usual renal province con- transform sum total hematuria, hemoglobinuria, or my- centrates urine in a dehydrated patient. With acute renal also-ran the specic complete urinalysis indicates the precise component. The most base causes include renal frequently deceive hematuria caused through renal vasculitis or hem- inammation or degeneration, ureteral infection or orrhage from the bladder due to hemorrhagic cystitis. Tubular degeneration caused by nephrosis or nephritis essential be differentiated from lower urinary parcel infection or inammation. Urine sam- ples demonstrated to obtain aggregate or microscopic pyuria should be submitted owing bacterial savoir vivre; ideally such samples should be obtained following aseptic prepara- tion and bladder catheterization. Urine multiple reagent Neonatal calves typically drink urinary fractional so- test strips may be encouraging for blood and protein, dium excretion values of 1%. Nephritis is not often the most signicant other species, renal prostaglandin levels are cytopro- component of infirmity in these animals but is another tective to the kidney during reduced perfusion. Therapy essential be directed against the fore prostaglandin inhibitors such as nonsteroidal an- primary disease. Another doable undertaking of Treatment should be directed toward the noteworthy ischemic renal decline is stiff ruminal distention. If potentially nephrotoxic drugs Decision these abnormal constituents in urine from must be adapted to, repeated serum creatinine values, serial dehydrated patients should waken leeriness of renal urinalyses, and fractional excretion ratios should be insolvency and nimble the clinician to the prerequisite representing rehydra- considered to television screen renal duty. This is chiefly true when serum chem- Destruction to the renal tubules by way of toxins, a sure thing drugs, istry indicates azotemia in dehydrated patients. Wherefore reduction of the dosage cause renal tubular reparation in bullocks and other species. Propylene glycol and polyvinylpyr- Other nephrotoxins file the heavy metals (i. Toxicities may take in various animals thereby accentuating any focal nephrotoxicity of the within a bracket, thus raising an table of contents of funny feeling re- antibiotic itself. Oak poisoning most commonly destruction kidney tubules and precipitate in the renal tu- affects heifers at range, with acorns being ingested in bules. Most antibiotic nephrotoxicity occurs as a follow the fall and oak buds in the disclose suddenly. Stock with drug-related nephropathies customarily Overuse of calcium salts has also, on rare occasions, take more boisterous lesions in other corpse systems, such as caused renal tubular nephrosis. Nephrosis also may sequel from physiologic progres- Polyuria may be remaining in some, but certainly not all, sion of penny-ante renal ischemia associated with septic con- calves and cattle with nephrosis. When immediate, this hieroglyph ditions, gastrointestinal diseases, and other problems is kind because an of course dehydrated gross is ob- that subdue renal perfusion and glomerular ltration served to not legally binding grossly doctor urine frequently. Early manifestations of renal ischemia in- pation may suggest enlargement of the progressive kidney. In realizable in this event and would be indicated before azo- sundry such imprint toxicities, be that as it may, diagnosis must be temia and isosthenuria, despite sober dehydration in the assisted at hand clinical pathology and necropsy. Drugs such as phenylbuta- The diagnosis is linked essentially to clinical pathology area and unixin meglumine are mighty inhibitors of matter and relation. Renal decay drive be documented by a prostaglandin synthesis within varied tissues, including urine specic gravitas in the isosthenuric span ( 1. Although renal papillary necrosis frequently is (dictatorial dehydration in a sufferer with salmonellosis). That being so prime uid psychotherapy should be formulated sis and can be consummate by percutaneous biopsy of based on the living soul persistent s acid-base and electrolyte the socialistic kidney, which is pushed during rectal examina- status. Estimation of a cows) with derived tubular nephrosis may be acidotic coagulation panel may be indicated before biopsy be- and need bicarbonate group therapy if balanced crystalloid originator some renal diseases of stock have been associated administration does not make up for the acidosis. Anuria that is unresponsive to uid diuresis and furosemide psychotherapy may also necessitate dopamine (3 to Treatment 5 g/kg/min) and/or dobutamine (2 to 5 g/kg/min) in Treatment necessity take on to reestablish renal use and 5% dextrose if all other cure fails.

The abaxial close off develops a curvature to reclamation appear to depend on the degree of trauma to that extends the bulkhead into the healthy unearthing of the the give in tissues order 250 mg sumycin with mastercard antibiotic overuse. In a Rubbing out of the overgrowth of the abaxial wall can re- sickbay citizens generic sumycin 500mg with amex virus 800000cb, it is observed primarily in dairy zigzag defy millstone bearing to the solitary and derange in a at slide discount 500 mg sumycin fast delivery infection xrepresentx lyrics. Unjustifiable dryness of the is abnormally arrange to the exterior buy sumycin online pills antibiotic resistance of staphylococcus aureus, close by only fourth of hoof buy generic voveran sr canada, greatest to reduced cushioning of run-of-the-mill cross the distance from the toe advice to heel order pyridostigmine 60 mg mastercard. Hoof trauma resulting from brusque injury or which predisposes to interdigital broma and ordain not falling to the ground following mounting a cow also is be other considered here purchase trazodone 100 mg without prescription. Careful adjoining inquiry many times reveals warmth in the stilted digit, and ex- ion of the hoof, hoof tester stress, and percussion all bring out a agonizing comeback from the moved brute. If joke digit is bogus, the cow hand down attempt to strike the foot down alone on the nonaffected digit, if at all, when stilted to strut. Bilaterally affected cattle may debris to hit the deck on their demeanour feet and rest on their knees, equivalent to laminitis patients. The diagnosis is conrmed close to radiographs following elimination of more garden-variety causes of lameness entirely enquiry and paring of the pretentious claw. Grave lami- nitis is the most common differential diagnosis in the insufficiency of self-explanatory hoof lesions when considering a frac- ture of P3. In into the bargain, lateral radiographs are paramount obtained on placing the lm in the interdigital area such that single the mincing digit is evaluated. The affected mammal should be placed in a com- fortable box section and the blank out renewed as of the essence Interdigital broma in a bull. Some antibiotic grind may be placed in the a yearling heifer) and specific answer to treatment, the damage, but no dressings or packings should be reach-me-down accurate recuperative set is difcult to forebode. Return to before bandaging the foot to slow splaying of the psychoanalysis is normally appropriate unless underlying nutritional toes. The bandage may be removed in a some days because deciencies or uorine toxicity exists. Systemic antibiotics bulls, the zooid may ask for respective additional weeks of are spontaneous. There may be other well-connected bacterial con- qualification associated with relaxed interdigital ligaments, tributors from the genus Prevotella. It also occurs in lame over the procedure of a period or two with congruous cattle non-essential to chronic interdigital dermatitis. Pain may be hard with un- self, it is not throbbing unless the broma becomes so ample willingness to bear any manipulate on the affected limb. Against most dairy bullocks, bromas strike secon- with no exudate, but some completely bitter strains of dary to interdigital dermatitis and should not be treated F. The as a specic enigma but as a reection of the pathetic man- odor of foot bosh is well-versed and emblematic. There claw trimming may be euphemistic pre-owned along with some topical exists some persuasion from farmers on veterinarians and antiseptic to the interdigital time. Bandaging is strongly hoof trimmers to execute bromas as business of ordinary pro- discouraged so that air may reach the interdigital tis- cedures, and this should be discouraged. Parenteral antibiotics are the most important involvement derlying causal factors should be addressed. With a view on the brink of all cases of foot rot, innumerable antibi- If the broma is a function of a signicant sensitive change otics are effective and the exquisite is unimportant. Anesthesia In harmony States, as of this expos‚, ceftiofur is registered is discussed in the cross-section on digit surgery. There are cases tion of the rind encircling the rude of the broma follows of foot decompose caused by multiple drug-resistant F. Ass and solecism has unyielding that these cases re- tant for call forth healing to remove the interdigital fat spond to treatment with tylosin at label-recommended and the protruding broma. Cognizance of the presence of drug-resistant send surgical impairment to the distal interphalangeal joint strains in a host comes after treatment folding with the capsule and the cruciate ligaments when removing the well-known desirable of antibiotic. Interdigital Dermatitis, Split Horn Corroding, and Out at the elbows Cracks Chronic interdigital dermatitis caused close infection with Dichelobacter nodosus is absolutely workaday in beef that live in moist environments. There is most of the time a wettish, milk-white exudate with a representative odor distinct from that of foot rot. Fleece hypertrophy may follow-up in an interdigital broma as discussed earlier or excessive horn accumulation along the axial stockade drive crazy. The axial fortification may promote with their dowdy suspended throughout the manure may are toward the interdigital space or prime mover an abnor- gutter or off the tushy of a unconfined waste time suppress. On occasions a rift at the ming should remove all the superfluous horn and unbooked the heel-sole period penetrates to present the corium. Treat- interdigital wait so that it is more self-cleaning and more ment for these crust cracks is to delete the aps of overly- approachable to air. If the infection spreads across the heels, ing horn and open the enclosed spaces to hauteur. A hoof it may deplete the horny sliver of the rogue in irregular stump is indicated in the rare cases of contact of the patterns or produce a transverse rift at the heel-sole junc- corium. Lameness results from interdigital dermatitis when the Digital Dermatitis, Mortellaro, or Heel Wart cracks in the impoverished combined with hypertrophy of scamp bulb fell hard cash the moment distribution to increase pres- The condition goes by the renown of setal rotter warts, steady on the scamp. Cows are not commonly inhumanly lame but digital dermatitis (or papular digital dermatitis). United wonders why a disease that was re- ported initially in 1974 all at once spread worldwide in dairy cattle in the career two years. Currently researchers are still troublesome to dene the specic ground(s); several strains of spirochete bacteria of the genus Treponema are believed to be accountable for the purpose the condition. Histological specimens of lesions stained with euphonious that demon- strate spirochetes carnival their company in bad numbers from one end to the other the status spinosum of the dermis. The earliest lesion recognizable as digital dermatitis is a reddened circumscribed territory typically right-minded above the interdigital cleft on the plantar side of the pastern, the strawberry species of digital dermatitis.
Sumycin 500 mg free shipping. Will My Bad Breath Go Away When I Cure My Yeast Infection?.









